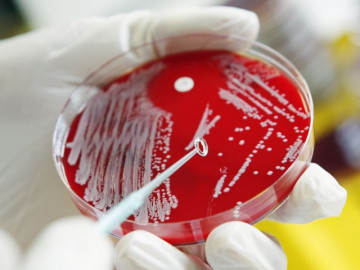
Có trẻ nhỏ mắc, tử vong vì nhiễm “vi khuẩn ăn thịt người”, cần làm gì để phòng bệnh này tuyệt đối?

Theo các bác sĩ, vi khuẩn "ăn thịt người" trong y khoa không phải bệnh khiến nhiều người dân hốt hoảng trong thời gian gần đây.
Whitmore không phải vi khuẩn "ăn thịt người"
Trước thông tin liên tiếp nhiều trường hợp mắc bệnh Whitmore do vi khuẩn "ăn thịt người" khiến người dân hoang mang, các chuyên gia y tế đã lên tiếng trấn an, giải đáp cụ thể về loại vi khuẩn này và sự thật hoàn toàn không giống như nhiều người nghĩ.
Bác sĩ Trương Hữu Khanh, Trưởng khoa Nhiễm Thần kinh, Bệnh viện Nhi đồng 1 TP.HCM cho biết: “Thực ra vi khuẩn "ăn thịt người" trong y khoa có bàn nhưng không phải là bệnh mà mạng xã hội đang hoảng, đang bàn. Từ "ăn thịt người" là do vi khuẩn này tiết ra 2 độc tố gây thối rữa thịt. Nhưng vi khuẩn này có tên là Aeromonas hydrophila. Chúng có khả năng làm hoại tử mô khi chúng gây nhiễm, nên chúng ta có cảm giác như chúng đang "ăn thịt".
Còn bệnh khiến nhiều người đang hốt hoảng trên mạng có tên Whitmore (hay bệnh Melioidosis) và do vi khuẩn Burkholderia pseudomallei gây nên. Bệnh Whitmore đã có từ lâu, do vi khuẩn từ vết xước trên da đi vào máu gây nhiễm trùng máu hay áp xe hoại tử nhiều cơ quan trong đó có da và vùng da bị bệnh gây loét hoại tử nên bị nhiều người gọi là "ăn thịt người".
Bác sĩ Trương Hữu Khanh, Trưởng Khoa Nhiễm Thần kinh, Bệnh viện Nhi đồng 1 TPHCM. Ảnh: Thiên Chương.
Đồng quan điểm với bác sĩ Khanh, tiến sĩ Nguyễn Hồng Vũ, Viện Nghiên cứu ung thư, City of Hope, California, Mỹ thông tin thêm: "Thực ra, gán cho con vi khuẩn này là “ăn thịt người” (flesh eating bacteria) là không đúng. Vi khuẩn gây bệnh Whitmore là vi khuẩn có tên là Burkholderia pseudomallei, gây chết người do viêm phổi, nhiễm trùng máu và trong trường hợp nặng nhất là suy nội tạng khi không được điều trị kịp thời và đúng cách. Vì vi khuẩn này kháng nhiều loại kháng sinh thông thường, trong khi đó hệ miễn dịch của cơ thể không chống lại chúng một cách hữu hiệu."
Vi khuẩn này đã được trung tâm kiểm soát và phòng chống dịch bệnh của Mỹ (CDC – Centers for Disease Control and Prevention) liệt kê vào đối tượng có nguy cơ sử dụng như khủng bố sinh học (Bioterrorism) vì tính nguy hiểm của chúng. Theo số liệu thống kê CDC cho biết, người nhiễm vi khuẩn B. pseudomallei nếu không được điều trị, cứ 10 người thì có tới 9 người chết. Trong khi đó, những người được điều trị đúng kháng sinh thì vẫn có khoảng 4 trong số 10 người tử vong, còn nếu được điều trị trong cơ sở y tế với chăm sóc tích cực có thể giảm tỉ lệ người chết còn dưới 2 trong 10 người.
Bệnh Whitmore do vi khuẩn từ vết xước trên da đi vào máu gây nhiễm trùng máu hay áp xe hoại tử nhiều cơ quan, gây loét hoại tử nên bị nhiều người gọi là "ăn thịt người". (Ảnh minh họa)
Bệnh Whitmore thường xảy ra ở miền bắc Australia, Papua New Guinea, Đông Nam Á, ở hầu hết các tiểu lục địa Ấn Độ, ở miền nam Trung Quốc, Hồng Kông và Đài Loan. Ở những vùng này, B. pseudomallei có trong đất và nước mặt. Hầu hết dịch bệnh xuất hiện nhiều vào mùa mưa.
Theo TS Vũ, đường lây nhiễm bệnh chủ yếu là do hít phải bụi bẩn, giọt nước hoặc uống phải nước bị ô nhiễm chứa vi khuẩn này và tiếp xúc với đất bị ô nhiễm chứa vi khuẩn, đặc biệt là qua các vết trầy xước trên da. Việc lây nhiễm giữa người với người rất khó xảy ra trong quan hệ thường ngày, chỉ có thể xảy ra qua quan hệ tình dục, hoặc sử dụng chung kim chích.
Bệnh Whitmore dễ nhầm lẫn với các bệnh thông thường
“Do không có hội chứng lâm sàng bệnh lý đặc hiệu và các triệu chứng lâm sàng thường rất giống với các bệnh khác như bệnh lao phổi, bệnh cúm, sốt,… Vì thế nhiều trường hợp đã không phát hiện bệnh này sớm mà nhầm lẫn với các bệnh khác. Thời gian ủ bệnh thường 1-21 ngày, trung bình là 9 ngày. Mức độ nghiêm trọng của bệnh dựa vào tình trạng nhiễm trùng. Người bệnh tiểu đường, bệnh phổi mãn tính, bệnh thận mãn tính và ung thư có nguy cơ tử vong cao hơn khi nhiễm vi khuẩn này”, TS Vũ nói.
Việc lây nhiễm Whitmore giữa người với người rất khó xảy ra trong quan hệ thường ngày, chỉ có thể xảy ra qua quan hệ tình dục, hoặc sử dụng chung kim chích.
Theo bác sĩ Vũ Vũ, Khoa Cấp cứu, Bệnh viện Nhân dân 115 TP.HCM, các thể bệnh của Whitmore gồm có:
- Nhiễm trùng ở phổi: Thể bệnh phổ biến nhất (trên 50%), vi khuẩn này gây viêm phổi rất giống lao phổi. Triệu chứng cấp tính có thể bao gồm sốt cao, ho, khạc đờm, ớn lạnh và suy hô hấp có hoặc không có sốc gây viêm thuỳ trên, áp xe, hình ảnh giống hang lao.
- Nhiễm trùng da nơi tiếp xúc: Tổn thương đại thể gây ra (trông giống ăn thịt người) có mủ màu tím. Thông thường, những tổn thương này không đáp ứng với kháng sinh đường uống trước khi nhập viện.
- Nhiễm trùng huyết: Là thể nặng nhất và dễ gây tử vong nhất. Trong nghiên cứu của Darwin 55% bệnh nhân bị nhiễm khuẩn huyết với tỷ lệ tử vong 20%.
- Ngoài ra còn có nhiễm trùng tại các cơ quan khác như niệu sinh dục, viêm tuyến yên, nhiễm trùng xương khớp, viêm tuỷ, nhiễm trùng não..
Khi bệnh nhân mắc Whitmore sẽ rơi vào quá trình bệnh kéo dài và thường cần một quá trình điều trị kháng sinh kéo dài, bao gồm 10-14 ngày dùng ceftazidime, meropenem hoặc imipenem trong 3-6 tháng. Sự tuân thủ điều trị là rất quan trọng vì để tránh biến chứng nghiêm trọng của bệnh.
Phòng bệnh Whitmore như thế nào?
Do vi khuẩn có khả năng tồn tại trong tế bào nên khả năng bệnh tái phát sau một khoảng thời gian sau điều trị là có thể xảy ra. Tỉ lệ tái phát của bệnh là từ 5% đến 25% trường hợp. Hiện nay chưa có vaccine để chủng ngừa cho bệnh này. Do đó, bác sĩ Vũ khuyến cáo người dân cần:
- Tránh bơi trong nước ngọt hay tiếp xúc trực tiếp với bùn đất ướt, ruộng ở vùng dịch nhất là vào mùa mưa.
- Nên trang bị đồ cao su ngăn ngừa như ủng, găng tay.
- Tránh tiếp xúc với nước, bùn đất nếu có trầy xước da đặc biệt là trẻ nhỏ chơi đùa. Nếu bị trầy xước, lập tức rửa sạch dùng thuốc sát khuẩn.
- Sử dụng nước ăn và uống nước đun sôi, nước đóng chai.
- Nếu có triệu chứng nghi ngờ có bệnh tới bệnh viện để thăm khám